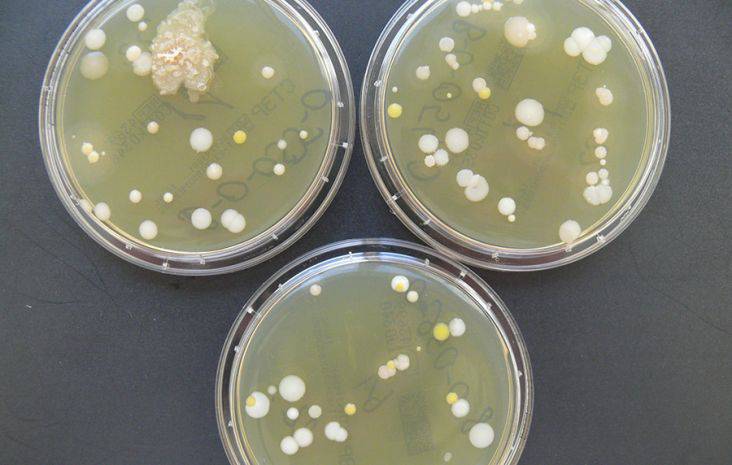
badanie mikrobiologiczne leków

Opis działalności firmy Bio-Chic sp. z o.o. w Warszawa
W Bio-Chic wykonujemy badania mikrobiologiczne dla branży farmaceutycznej oraz kosmetycznej. Nasza siedziba znajduje się w Warszawie. Zapraszamy do kontaktu.
Produkty i usługi
W Bio-Chic działamy na rynku już od 1987 roku. Misją naszej firmy jest wyspecjalizowany outsourcing badań mikrobiologicznych, a naszą filozofią jest wspieranie klientów instytucjonalnych, reprezentujących branżę farmaceutyczną, medyczną, kosmetyczną i spożywczą, w osiąganiu wysokich standardów produkcji poprzez najwyższej jakości usługi mikrobiologiczne i doradcze.
Dodatkowo w laboratorium wykonujemy:
- badania czystości mikrobiologicznej produktów i surowców kosmetycznych,
- wody produkcyjnej,
- wody przeznaczonej do spożycia przez ludzi oraz wody na pływalniach,
- opakowań,
- testy ochrony przeciwdrobnoustrojowej,
- badanie skuteczność środków dezynfekujących,
- badanie skuteczność procesów sterylizacji.
Oferujemy wysoko wykwalifikowaną kadrę mikrobiologów otwartych na nowe pomysły i inspiracje, gwarantujących usługi na najwyższym poziomie.
Naszą działalność prowadzimy zgodnie ze standardami ISO 9001, PN-EN ISO/IEC 17025:2005+Ap1:2007 oraz GMP.
Zapraszamy do współpracy.
Zasięg działania
Firma Bio-Chic sp. z o.o. z lokalizacji: Warszawa świadczy usługi m.in. w wymienionych obszarach:
mazowieckie